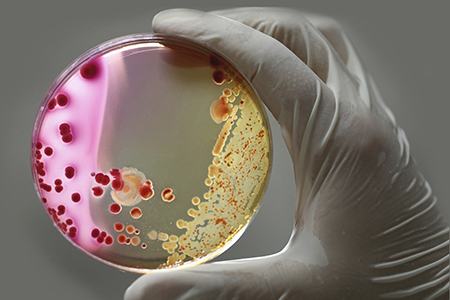
How Antibiotics Affect Your Microbiome

The human gut microbiome is a complex, highly-evolved commensal community with an integral role in your response to disease and how well you maintain homeostasis. While commensal bacteria vary from person to person, a person's specific microbiome should contain the same relative percentage of bacterial species over their lifespan.
The human gut microbiome is a complex, highly-evolved commensal community with an integral role in your response to disease and how well you maintain homeostasis. While commensal bacteria vary from person to person, a person's specific microbiome should contain the same relative percentage of bacterial species over their lifespan. The balance of this community can be altered for weeks, months, and even years depending on diet, environmental factors, stress, and medications. Without proper gut microbiome function, host immunity and resistance to pathogenesis may be decreased, along with the ability to absorb key nutrients from the diet2.
How Antibiotics Disrupt the Microbiome
The medications most likely to disrupt the normal gut microbiome are antibiotics, with broad-spectrum antibiotics contributing most to microbiome disturbance. The extent of these side effects depends on multiple factors:- Type of Antibiotic
- Dosage
- Length of Treatment
- Route of Administration
- Time for Elimination
- Mechanism of Action1
Broad-Spectrum Antibiotics
Broad-spectrum antibiotics are antibiotic medications that are effective against both gram-positive as well as gram-negative bacteria3. These antibiotics are commonly used when a bacterial infection is present, but there is a lack of time or resources and treatment needs to be administered immediately.Throughout history, broad-spectrum antibiotics have saved countless lives and enabled advancements in surgery and treatment for hospital-acquired infections. However, while extremely useful, broad-spectrum antibiotics have been associated with acquired allergies and are the main contributing cause of the antibiotic resistance crisis. The most common broad-spectrum antibiotics used in humans are:
- Ampicillin
- Amoxicillin, Amoxicillin/clavulanic acid (Augmentin)
- Quinolones (e.g. ciprofloxacin)
- Tetracyclines
- Chloramphenicol
- Clindamycin
- Trimethoprim/sulfamethoxazole (Bactrim)
Narrow-Spectrum Antibiotics
Narrow-spectrum antibiotics have been shown to be effective when the bacterial genus or species is known. However, clinicians need to diagnose the offending bacteria rapidly and accurately before an infection becomes too severe.Clinicians need additional resources and training to understand what types of bacterial species can be targeted with narrow-spectrum antibiotics and when these can be effective4.
Clinical Impact of Antibiotics on Microbiome
One key example of antibiotic-induced microbiome disturbance is in patients who have been treated with clindamycin5. While clindamycin may effectively treat recurrent strep infections, diabetic foot infections, and the sexually-transmitted bacteria Chlamydia, its detrimental effects on the gut microbiome can result in the colonization of pathogenic bacteria such as Clostridium difficile6.Small amounts of C. difficile can exist in humans without apparent harm, but when antibiotic treatment wipes out beneficial gut bacteria, C. difficile can overgrow and lead to excessive diarrhea and colitis7. Additionally, long-term shifts (two years) in the composition of the gut microbiome have been found even after short-term (seven-day) administration of clindamycin8,9.
Depending on the length of the antibiotic treatment, the age of the patient when administered, and the type(s) of antibiotics used, the short-term and long-term effects can differ in type and severity. Short-term effects are usually limited to the duration of the treatment and resolve within three months, while long-term effects can persist for up to two years past the antibiotic treatment8,10.
Short-Term Effects
- Decreased colonization by commensal bacteria
- Alterations in the composition of normal gut flora
- Disturbances in metabolism and absorption of nutrients
- Overgrowth of yeast (S. cerevisiae) and/or C. Difficile
- Increased susceptibility to infections
Long-Term Effects
- Persistence of antibiotic resistance genes (ARGs) in the gut microbiome
- Recurrent C. difficile infections
- Loss of microbial diversity and representation of specific taxa

















.jpg)

.jpg)
.jpg)
.jpg)
.jpg)





.jpg)


.jpg)
.jpg)




.jpg)





.jpg)

.jpg)





